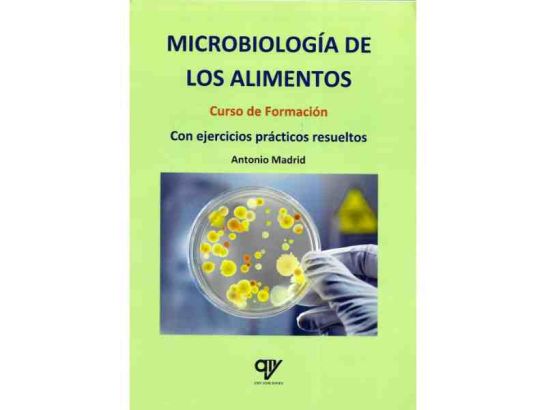

Microbiología de los Alimentos. Curso de Formación. Con Ejercicios Prácticos Resueltos
Explora el fascinante mundo de la microbiología alimentaria con ejercicios prácticos resueltos. Ideal para profesionales y cursos de formación.
Información del fabricante:
Nombre o empresa: Pendiente de actualizar
Email: Pendiente de actualizar
Dirección postal: Pendiente de actualizar
Localidad: Pendiente de actualizar
País: Pendiente de actualizar
Información de la persona responsable:
Nombre o empresa: Pendiente de actualizar
Email: Pendiente de actualizar
Dirección postal: Pendiente de actualizar
Localidad: Pendiente de actualizar
País: Pendiente de actualizar
Advertencias e información de seguridad del producto:
El producto cumple con el Reglamento de Seguridad General de los Productos.
La microbiología de los alimentos es un tema fascinante que abarca el estudio de los microorganismos que influyen en la calidad y seguridad de los alimentos que consumimos a diario. Este curso de formación ofrece una completa perspectiva sobre bacterias, levaduras, mohos y virus, desde su estructura hasta sus diferentes aplicaciones en la industria alimentaria.
CARACTERÍSTICAS
- Explora en profundidad la diversidad de microorganismos presentes en los alimentos.
- Analiza tanto los beneficiosos, como los perjudiciales para la salud.
- Incluye ejemplos prácticos de bacterias utilizadas en la producción de alimentos como el yogur, queso, vino y cerveza.
- Aborda casos especiales como el estudio de virus, como el Covid-19, que representan un desafío en la industria agroalimentaria.
- Ideal como material base para cursos de microbiología alimentaria.
- Contiene ejercicios prácticos resueltos para facilitar la comprensión de los conceptos.
- Relevante para profesionales de la alimentación, laboratorios, organismos oficiales y centros educativos relacionados con la tecnología alimentaria y microbiología.
DETALLES TÉCNICOS
- ISBN: 9788412239478
- Páginas: 250
- Idioma: Español
- Editorial: XYZ Publicaciones
- Autor: Especialistas en Microbiología Alimentaria
- Formato: Tapa blanda
- Dimensiones: 20 x 25 cm
Sumérgete en el fascinante mundo de la microbiología de los alimentos con este completo curso de formación que te permitirá adquirir los conocimientos necesarios para comprender la importancia de los microorganismos en la industria alimentaria. Con ejercicios prácticos resueltos y un enfoque pedagógico, este libro se convierte en una herramienta invaluable para todos aquellos interesados en el ámbito de la alimentación, la seguridad alimentaria y la microbiología. Descubre cómo los microbios inciden en la calidad de los alimentos que consumimos y cómo podemos aprovechar su potencial de manera positiva en la producción de diversos productos. ¡Un recurso esencial que no puede faltar en tu biblioteca si te apasiona el mundo de la microbiología y la gastronomía!